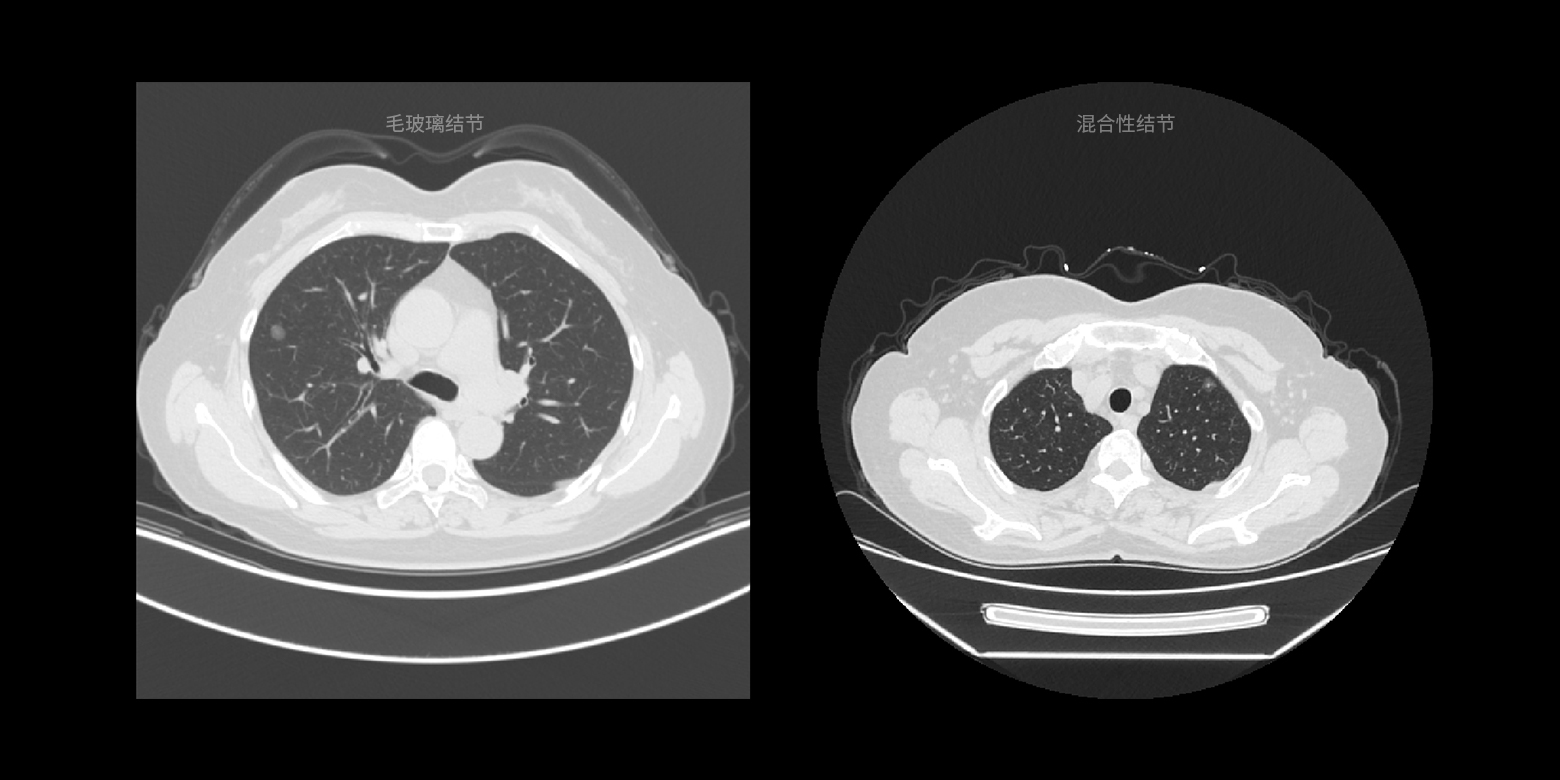

- 核心技術
- 以原創技術體係為根基,SenseCore商湯AI大裝置為核心基座,佈局多領域、多方向前沿研究,快速打通AI在各個垂直場景中的應用,向行業賦能。
- 01多模式的數據配準
- 02病灶部位的分割與量化
- 03病灶良惡性鑑別和病情分級
- 04病灶類型鑑別
- 05病灶/部位檢測與定位
01 / 05
多模式的數據配準
提供多模式的數據配準,可融合不同模式或不同序列的圖像數據,例如同一(器官)部位的CT、MRI、PET數據配準,進而精準地對病灶作定性或定量的風險分析。

02 / 05
病灶部位的分割與量化
支持針對小樣本的醫學數據進行訓練,實現对多種器官病變提供像素級別的精確圖像分割,並能自動根據關鍵信息進行量化分析和診斷,例如幫助醫生節省人手勾畫放療靶區、分割骨盆腫瘤等,更好的利用時間規劃和為客戶定制化手術。

03 / 05
病灶良惡性鑑別和病情分級
通過對以往複雜醫學診斷的不斷學習,可滿足大範圍的疾病篩查、病情分級判斷等等的需求,例如可分辨病變是良性或惡性的鑑別,病情的分級,例如十字韌帶撕裂的分級、肺結的惡性鑑別等。

04 / 05
病灶類型鑑別
根據國際通用的診斷指南以及頂級醫生的診斷經驗,針對臨床診斷的病變類型進行快速鑑別,降低相似病變的誤診概率。

05 / 05
病灶/部位檢測與定位
運用領先的計算機視覺技術,對 CT、MRI、病理等等醫學圖像中的器官/部位進行快速的檢測和定位,例如 MRI/CT 影像的椎間盤及椎骨的定位、CT 影像的肺結節檢測與定位、病理圖像的細胞檢測與定位等等,方便醫生參考並提供更準確的診斷,提高診斷效率。

- 多模式的數據配準
- 病灶部位的分割與量化
- 病灶良惡性鑑別和病情分級
- 病灶類型鑑別
- 病灶/部位檢測與定位
01 / 05
多模式的數據配準
提供多模式的數據配準,可融合不同模式或不同序列的圖像數據,例如同一(器官)部位的CT、MRI、PET數據配準,進而精準地對病灶作定性或定量的風險分析。

02 / 05
病灶部位的分割與量化
支持針對小樣本的醫學數據進行訓練,實現对多種器官病變提供像素級別的精確圖像分割,並能自動根據關鍵信息進行量化分析和診斷,例如幫助醫生節省人手勾畫放療靶區、分割骨盆腫瘤等,更好的利用時間規劃和為客戶定制化手術。

03 / 05
病灶良惡性鑑別和病情分級
通過對以往複雜醫學診斷的不斷學習,可滿足大範圍的疾病篩查、病情分級判斷等等的需求,例如可分辨病變是良性或惡性的鑑別,病情的分級,例如十字韌帶撕裂的分級、肺結的惡性鑑別等。

04 / 05
病灶類型鑑別
根據國際通用的診斷指南以及頂級醫生的診斷經驗,針對臨床診斷的病變類型進行快速鑑別,降低相似病變的誤診概率。
05 / 05
病灶/部位檢測與定位
運用領先的計算機視覺技術,對 CT、MRI、病理等等醫學圖像中的器官/部位進行快速的檢測和定位,例如 MRI/CT 影像的椎間盤及椎骨的定位、CT 影像的肺結節檢測與定位、病理圖像的細胞檢測與定位等等,方便醫生參考並提供更準確的診斷,提高診斷效率。









 返回
返回

